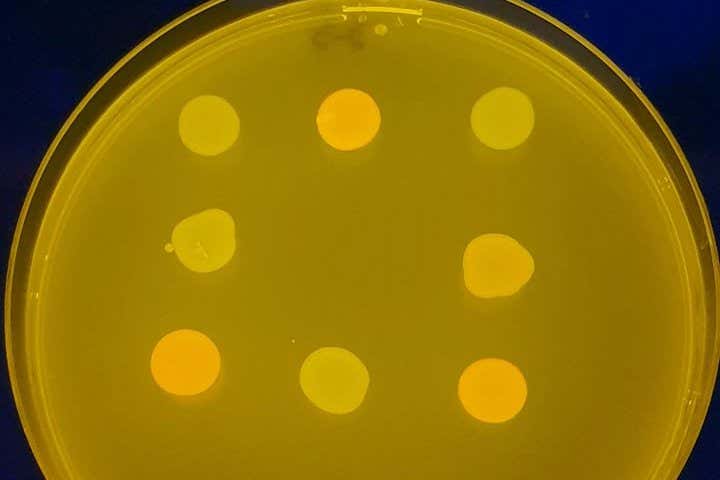
New Scientist. Science news and long reads from expert journalists, covering developments in science, technology, health and the environment on the website and the magazine.

Wells of bacteria representing a tic-tac-toe grid Alfonso Jaramillo/CSIC
For the first time, humans have played tic-tac-toe – also known as noughts and crosses – with bacteria. These were no ordinary bacteria, but E. coli extensively genetically modified and set up to act as a simple neural network, a form of artificial intelligence.
This approach could have all kinds of applications, from creating living materials capable of learning to making “smart” microbiomes, says Alfonso Jaramillo at the Spanish National Research Council.
He and his team started with an E. coli strain genetically modified to sense 12 different chemicals and respond…




